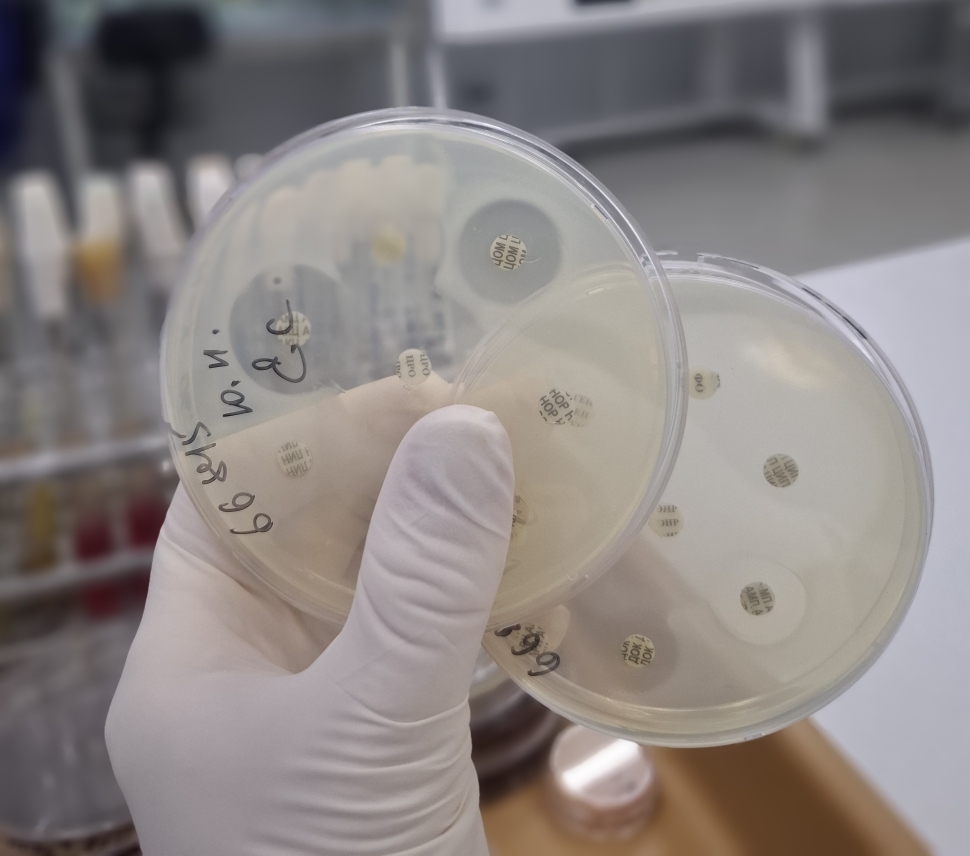

6
Камера: Galaxy A55 5G
ISO: 200
Выдержка: 1/100
Диафрагма: F/1.9
Фокусное расстояние: 5.54
Снято: 11 ноября 2025 08:32
Альбомы: микрофлора у попугая-01122025